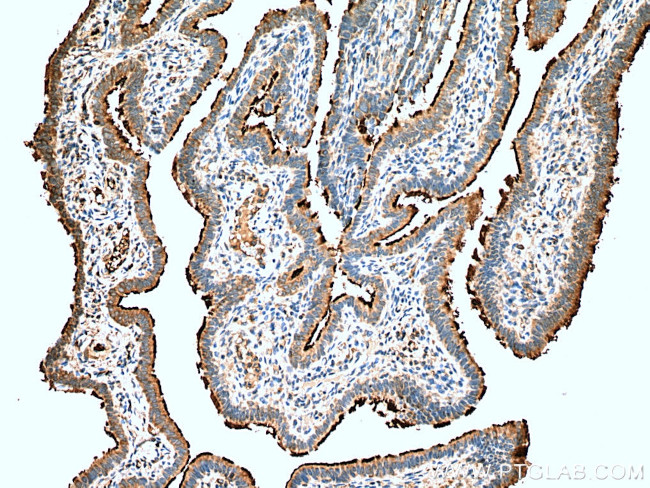
UNC45A Antibody in Immunohistochemistry (Paraffin) (IHC (P))

Search
Proteintech
UNC45A Polyclonal Antibody
{{$productOrderCtrl.translations['antibody.pdp.commerceCard.promotion.promotions']}}
{{$productOrderCtrl.translations['antibody.pdp.commerceCard.promotion.viewpromo']}}
{{$productOrderCtrl.translations['antibody.pdp.commerceCard.promotion.promocode']}}: {{promo.promoCode}} {{promo.promoTitle}} {{promo.promoDescription}}. {{$productOrderCtrl.translations['antibody.pdp.commerceCard.promotion.learnmore']}}
产品信息
19564-1-AP
种属反应
宿主/亚型
分类
类型
抗原
偶联物
形式
浓度
规格
纯化类型
保存液
内含物
保存条件
运输条件
产品详细信息
The antibody recognizes the C-term of UNC45A.
靶标信息
UNC45A, also named as SMAP1, acts as co-chaperone for HSP90. UNC45A prevents the stimulation of HSP90AB1 ATPase activity by AHSA1. It is a positive factor in promoting PGR function in the cell. It is necessary for proper folding of myosin and necessary for normal cell proliferation, normal myotube formation and myosin accumulation during muscle cell development. UNC45A plays a role in erythropoiesis in stroma cells in the spleen.
仅用于科研。不用于诊断过程。未经明确授权不得转售。
生物信息学
蛋白别名: GCUNC-45; general cell UNC45; Protein unc-45 homolog A; SMAP-1; smooth muscle cell associated protein-1; Smooth muscle cell-associated protein 1; Stromal membrane-associated protein 1; unc-45 homolog A; UNC-45A; unnamed protein product
基因别名: AW538196; GC-UNC45; GCUNC-45; GCUNC45; IRO039700; OOHE; RGD1305357; SMAP-1; SMAP1; UNC-45A; UNC45A
UniProt ID: (Human) Q9H3U1, (Mouse) Q99KD5, (Rat) Q32PZ3
Entrez Gene ID: (Human) 55898, (Mouse) 101869, (Rat) 308759